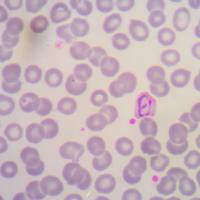
稳定细胞株筛选服务

万千商家帮你免费找货
0 人在求购买到急需产品
- 详细信息
- 文献和实验
- 技术资料

1. 一只成年爪蟾可以一次性获得上百个活性卵母细胞。这些细胞通过外科手术获得,不需处死爪蟾。一只爪蟾可以反复取卵多次。
2. 卵母细胞分离后,不需要很复杂的设备便可以实施培养。
3. 卵母细胞个头较大,肉眼可见,故而易于注射DNA和RNA。
4. 卵母细胞可以表达包括动植物在内不同种属的RNA。
5. 细胞自身具有的离子通道较少,主要为钙离子激活的氯离子通道,对要研究的通道影响很小。
6. 成熟的细胞,体积巨大,动物极呈深棕色,两个半球之间有一条清晰的亮环赤道带,直径大约为1200~1300μm,巨大的细胞核中含有大量的酶。单个卵母细胞每天可合成大约400ng的蛋白质,平均每小时合成20ng的蛋白质,不过不合成DNA。外源性的mRNA和内源性的mRNA互相竞争,约有高达50%的蛋白质可直接由外源性的mRNA翻译合成,平均每小时合成10ng蛋白质,因此可以说其是非常理想的表达外源基因的体系。
随着分子生物学和电生理技术的发展,卵母细胞表达系统在探究一些单细胞上不易表达记录的通道(如乙酰胆碱受体等配体门控通道)有着卓越的贡献。

风险提示:丁香通仅作为第三方平台,为商家信息发布提供平台空间。用户咨询产品时请注意保护个人信息及财产安全,合理判断,谨慎选购商品,商家和用户对交易行为负责。对于医疗器械类产品,请先查证核实企业经营资质和医疗器械产品注册证情况。
 文献和实验
文献和实验从毒品到抗抑郁药物,中国研究团队 Nature 揭示「K 粉
和记忆中发挥着重要的作用,NMDA 受体通常形成异四聚体复合物发挥功能,包括两个甘氨酸结合的 GluN1 亚基和两个谷氨酸结合的 GluN2(2A–2D) 亚基。研究者们利用了哺乳动物中系统表达的 GluN1–GluN2AEM 和 GluN1–GluN2BEM 受体,这两种 NMDA 受体是成年哺乳动物脑内表达最丰富的亚型。通过双电极电压钳(TEVC)实验验证了氯胺酮的亲和力,并通过冷冻电镜的结构解析,获得了分辨率分别为 3.5 Å 的 GluN1-GluN2A 和 4.0 Å GluN
细胞是动物和人体的基本组成单元,细胞与细胞内的通信,是依靠其膜上的离子通道进行的,离子和离子通道是细胞兴奋的基础,亦即产生生物电信号的基础,生物电信号通常用电学或电子学方法进行测量。由此形成了一门细胞学科-电生理学(electrophysiology),即是用电生理的方法来记录和分析细胞产生电的大小和规律的科学。 早期的研究多使用双电极电压钳技术作细胞内电活动的记录。现代膜片钳技术是在电压钳技术的基础上发展起来的。 1976年德国马普生物物理研究所Neher和Sakmann创建了膜片钳技术
膜片钳技术是在电压钳技术基础上发展起来的,电压钳是利用负反馈技术将膜电位在空间和时间上固定于某一测定值,以研究动作电位产生过程中膜的离子通透性与膜电位之间的依从关系。但电压钳只能研究一个细胞上众多通道的综合活动规律,而无法反映单个通道的活动特点,同时通过细胞内微电极引导记录的离子通道电流其背景噪声太大。膜片钳技术的优势是可利用负反馈电子线路,将微电极尖端吸附的1μm2至几个平方微米细胞膜的电位固定在一定水平上,对通过通道的微小离子电流作动态或静态的观察
 技术资料
技术资料暂无技术资料 索取技术资料